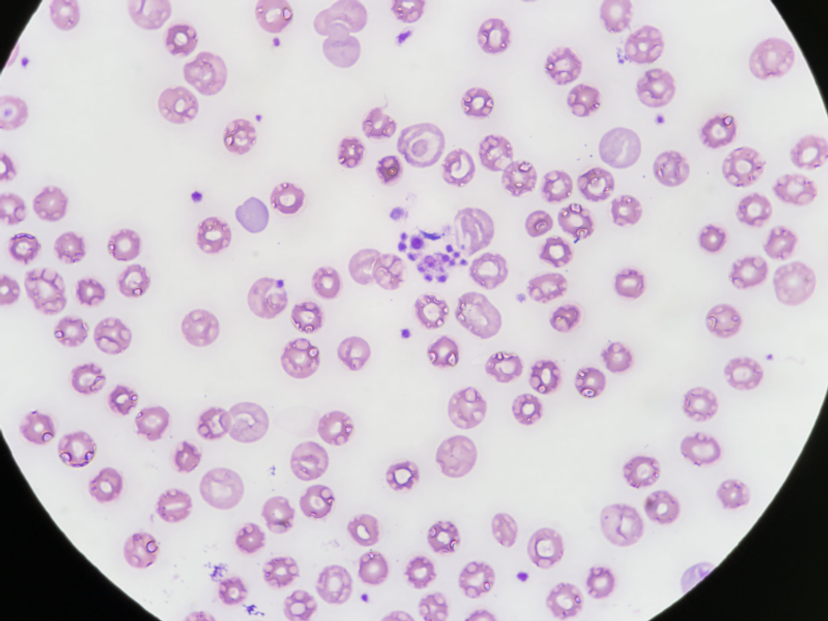

LIVE: Today's the day! Join us for our CLINICAL24 event
3 Dec 2024Editorial article
Since October 1st 2024, SelectScience has been hosting the world's largest, global online conversation for laboratory scientists and healthcare professionals. Over the following weeks since the campaign launched, we've heard from hundreds of scientists, healthcare professionals, societies, associations and manufacturers working in the medical laboratory field. You've told us what challenges you face, and we've explored together the technology solutions to overcome them. Today, December 3 is a one day celebration to highlight the amazing conversations, interviews, videos, webinars and more published as part of this discussion. So join us every hour throughout the day today as we share insightful stories, lessons and conversations from CLINICAL24.
----------------------------------------
10 PM - 12 AM
Thank you for celebrating with us during our CLINICAL24 24-hour event. It has been a fantastic day with so many of you joining us on our social media channels and here on SelectScience. We hope that the content and conversations shared have been insightful.
Clinical laboratories face many challenges, especially post-pandemic with budget constraints, too many administrative tasks, staffing shortages, and not enough information on AI/machine learning/digital transformation being the top four challenges named by med lab professionals around the world.
But as CLINICAL24 has also shown, the solutions to these challenges are either already available or they are currently being developed by diligent and passionate diagnostic companies, which have clear goals of helping the profession overcome them to deliver accurate and fast results to the patient. What CLINICAL24 has also highlighted, is that everyone involved in the industry cares very deeply about providing the best possible healthcare service.
By communicating across borders, disciplines and working groups, and sharing expertise and knowledge with others involved in the industry, we can advance healthcare together and ultimately, improve the lives of the patients that we serve.
----------------------------------------
8 - 10 PM
CLINICAL24 would not be as successful as it is without its official Ambassadors and supporters who are all vocal advocates of the medical laboratory profession. It also would not have been possible without the support of the diagnostic manufacturers who added their vital voices to the global conversation by providing the solutions to the challenges being faced by labs all around the world.
Official Ambassadors:
- Susan Dawson, Consultant, Speaker, Writer, recently retired from the role of Laboratory Administrative and Operations Director, Endeavour Health, Chicago
- Sten Westgard, Director of Client Services and Technology for Westgard QC
- Dr. Ron Daniels, NHS Intensive Care Consultant, Birmingham, UK, Executive Director and Founder of The UK Sepsis Trust
- Professor Joe El-KhouryAssociate Professor of Laboratory Medicine, Yale School of Medicine, Director, Clinical Chemistry Laboratory & Fellowship Program, Yale New Haven Health
- Dr. Frank Peacock, Associate Chair and Research Director for Emergency Medicine, Baylor College of Medicine
- Aida Noor, Founder and CEO of Biomedical Science & Beyond, Biomedical Scientist, Author, Public Speaker
- Dr. Vasiliki E. Kalodimou, Director at the Flow Cytometry-Research and Regenerative Medicine Department of IASO Maternity-Pediatric and Research Hospital in Athens, Greece
- Duncan Porter, Vice President – Head of the Immulite, Plasma Proteins and Syva Business Segment, Siemens Healthineers
- David Wells, Chief Executive, Institute of Biomedical Science (IBMS)
Official supporters:
- The UK Sepsis Trust
- The Global Sepsis Alliance
- The Institute of Biomedical Science (IBMS)
- The Association of Diagnostics for Laboratory Medicine (ADLM)
- The Applied Microbiology Institute (AMI)
Official sponsors:
- Scopio Labs
- Beckman Coulter Diagnostics
- The Binding Site
- ELITechGroup, a Bruker company
- Inflammatix
- SCIEX
- EuroImmun
- Revvity
- NuAire
- CLSI
- Abbott
Additional contributors and interviewees:
- Beckman Coulter Microbiology
- Siemens Healthineers
- Owlstone Medical
- Carepoint Dx
- Sysmex USA
- QuidelOrtho
- MicrosensDx
- Thermo Fisher Scientific
--------------------------------------------------------------------------------
7 PM

NuAire provides several resources to aid in the selection, maintenance, and retirement of your biosafety cabinets
Ensuring the safety of staff is critical to all clinical laboratories. Throughout CLINICAL24, lab safety specialists Nuaire, have been sharing information with us on how to conduct crucial risk assessments, select a biosafety cabinet and create a training program to meet your individual needs. Download these whitepapers today to learn more:
Biosafety cabinet selection in the context of risk assessment
Building a custom biosafety cabinet around your laboratory automation equipment
Creating a biosafety cabinet training program
----------------------------------------
6 PM
Personalized medicine

Watch industry expert, Duncan Porter, as he highlights 8 key trends in the clinical field
In this video, Duncan Porter, with 25 years of clinical diagnostics industry experience, highlights 8 key trends shaping the future of clinical laboratory medicine. We are sure you won't be surprised to see molecular diagnostics and genomics on that list. As Duncan says, 'we are on the cusp of personalized medicine, where molecular diagnostics, especially genomics, is driving this shift'.
Watch the video: 8 key trends shaping the future of clinical laboratory medicine
Learn more about personalized medicine with these informative resources from Revvity:
Redefining the genomics landscape to navigate the future of personalized medicine
Driving precision oncology with chemagic technology
----------------------------------------
5 PM

Artificial intelligence
In our Future Lab conversation we explored solutions that use artificial intelligence (AI) to solve challenges faced by medical laboratory scientists.
Insightful articles for immunologists:
AI-enhanced evaluation software for immunofluorescence microscopy
Complete IFA automation with AI-enhanced evaluation
----------------------------------------
4 PM

The CLSI Fact Sheet is a good place to start if you have questions about the FDA's final rule
The FDA ruling on LDTs went into effect May 2024 and the requirements will be phased in stages beginning May 2025 through May 2028. Many of you are searching for more information on how to prepare your laboratories for this big change. A great place to start is with this very useful and informative fact sheet from the Clinical and Laboratory Standards Institute (CLSI). This LDT Fact Sheet is a first step toward addressing those questions and gaining a sense of control over a changing regulatory environment.
FDA LDT final rule implementation fact sheet
Then read this informative article from SCIEX: What the FDA’s final rule on LDTs means for clinical laboratories
----------------------------------------
3 PM
3pm is sepsis awareness hour! During CLINICAL24 we have been hearing about current challenges around sepsis diagnostics and management, and exploring new diagnostic tests available to help reduce unnecessary deaths from this killer disease.

----------------------------------------
2 PM
The high-sensitivity immunoassay story
Note from the Managing Editor, Sonia Nicholas.
Beckman Coulter Clinical Diagnostics is the Platinum Sponsor of CLINICAL24's Innovation Hub and we have spent the last few months learning about the value of high-sensitivity immunoassays.

Don't miss our upcoming live discussion Forum, during which our panel of experts will discuss the working example of high-sensitivity troponin immunoassays. Joining the panel will be Dr. Frank Peacock, Emergency Physician at Baylor College of Medicine, Tracy Mangunlay, Laboratory Services Executive, Adentist Health and Sten Westgard from the famous Westgard QC Laboratory. There will be learnings for all lab scientists, lab professionals and clinicians involved in immunoassay testing. Register today here.
You can also learn more about high-sensitivity immunoassay with the following resources:
Guest editorial: Enhancing quality in clinical laboratories with Six Sigma
Guest editorial: Challenges to Alzheimer's disease diagnosis and the emerging treatment landscape
Poster download: Enhanced sensitivity of Beckman Coulter DxI 9000 reduces sample & reagent use
Poster download: Beckman Coulter DxI 9000 meets CLIA 2024 PT goals with top Six Sigma performance
----------------------------------------
1 PM
The digital morphology story
Note from the Managing Editor, Sonia Nicholas.
Scopio Labs is the Platinum Sponsor of CLINICAL24's Future Lab conversation and we have loved learning all about this company's exciting new digital morphology solution for hematology laboratories.
This technology has the potential to completely change the future of morphology and I know many laboratory managers are keen to learn more. Throughout CLINICAL24, we have published supporting information and hosted several key events for laboratory scientists, managers and healthcare professionals.
Earlier this month I hosted a live webinar with a panel of experienced laboratory experts working at the forefront of laboratory management. Watch on demand today: Advancing Healthcare Forum on challenges and opportunities in hematology
You can learn more about Scopio's digital morphology solution by watching this on-demand webinar: Revolutionizing hematology with AI and full-field morphology
Supporting resources:
Infographic: Reduce turnaround time for blood smear review by up to 59%
Case study: Swiss lab cuts blood smear analysis time by 57%
eBook: The clinical impact of Full-Field technology in hematology
----------------------------------------
12 PM
As well as exploring new technology, during CLINICAL24, we have reflected on how our favorite lab workhorses efficiently and accurately support labs in delivering results. One such technology is the Aerospray slide stainers from ELITechGroup, a Bruker company. These intruments, primarily for hematology and cytology labs, enable customized slide staining for a more detailed visualization of cell morphology across many sample types, such as blood, bone marrow, pleural fluid, and synovial fluid.

SelectScience reviewers say:
"Works great! A much needed improvement from what we had."
"I use the stainer daily for cytology staining. It's fast and efficient. Easy to load slides. It's quick to change reagents. The slides come out consistently. Great user-friendly product."
"Stains slide perfectly each and every time so we can produce accurate results."
Additional resources:
Download this infographic to learn more about customized Aerospray® slide staining
Watch this brand new, exclusive interview with Bryan Keisel, Service Manager at ELITechGroup, a Bruker Company: Enhance lab efficiency and precision with Aerospray slide staining technology.
----------------------------------------
11 AM
Clinical mass spectrometry event today:
Register for today's CLINICAL24 webinar at 4pm GMT with The Binding Site to learn all about a brand new clinical mass spectrometry solution for monoclonal gammopathy assessment. This webinar will be valuable anyone wishing to keep up to date with the latest innovations in the field: Transforming M-protein diagnostics with mass spectrometry using the EXENT® System
Key learning objectives
- Understand the role of mass spectrometry (MS) in monoclonal protein testing
- Explore the analytical performance of the EXENT System using MALDI-ToF MS technology
- Understand the potential clinical impact of mass spectrometry for patients with monoclonal gammopathies

@123rf ©liudmilachernetska
Who should attend?
Laboratory professionals, hematologists, and primary care professionals who would like to learn more about the latest innovation for monoclonal gammopathy assessment.
The EXENT Analyser and Immunoglobulin Isotypes (GAM) for EXENT Analyser are only commercially available in Australia, New Zealand, United Kingdom, Switzerland and the EEA. The products are not commercially available in the USA or China, future commercial availability cannot be guaranteed.
Product availability is subject to country specific regulatory requirements. Contact your local representative for availability in your country.
----------------------------------------
10 AM
The Clinical Laboratory of the Future: Clinical laboratories must continuously stay informed of the latest technology advances and medical advancements, to deliver the best possible patient care. It is also crucial to future proof the laboratory to ensure that a reliable and efficient service can continue to be delivered.

During CLINICAL24, we discuss the challenges facing clinical laboratories, from staffing issues to funding problems, and explore the technology solutions to help laboratories of the future overcome them.
Watch a case study video on future proofing the lab with next-generation Abbott automation
Find out what does the FDA's final rule on LDTs mean for clinical laboratories?
Explore the Laboratory of the Future CLINICAL24 Feature Page----------------------------------------
9 AM
Healthcare systems all around the world are under pressure from a wide range of challenges, but the goal to deliver the best possible healthcare continues to drive innovation in the field.

For clinical laboratories to be able to accurately diagnose and monitor a vast range of disease states, this innovation is essential. During CLINICAL24 we have been exploring the very latest advances in the field, from biomarker discovery to the latest immunoassay development.
Read a guest blog on enhancing quality in clinical laboratories with Six Sigma
Learn about challenges to Alzheimer's disease diagnosis and the emerging treatment landscape
Explore the Innovation Hub CLINICAL24 Feature Page----------------------------------------
8 AM
The medical laboratory plays an essential role in the diagnosis, management, and treatment of patients, often in critical situations. It is vital that laboratories perform laboratory testing quickly and accurately, sometimes at the point-of-care, and send accurate, reliable results back to the medic making important patient decisions.

During CLINICAL24 we interviewed laboratory professionals and industry advocates to explore challenges facing this essential service.
Watch Sten Westgard discussing the challenges of quality control in modern laboratory diagnostics.
Read about a breakthrough technology to revolutionize sepsis diagnostics.
Explore the Essential Diagnostics CLINICAL24 Feature Page----------------------------------------
7 AM
During CLINICAL24 we've been giving you, our members, the chance to submit your own guest blog posts. We've loved hearing all about your daily tasks and responsibilities, the challenges you face and how you are overcoming them. You can find the guest blogs at the bottom of on our CLINICAL24 feature pages. To share your own blog post, take our survey during which you'll be asked if you'd like to submit an editorial.

Laboratory professionals from around the world are sharing their guest blog posts with us during CLINICAL24
----------------------------------------
6 AM
A note from the Managing Editor: Hi everyone, thank you for joining us today for our one-day celebration of CLINICAL24, our campaign to highlight challenges being faced by clinical laboratories, and exploring the technology solutions to overcome them.

Sonia Nicholas, Managing Editor and Clinical Lead, SelectScience
CLINICAL24 has been running since October 1st and we’ve had some hugely valuable conversations, covering all aspects of laboratory services, from clinical chemistry, to microbiology, to hematology around technologies such as high sensitivity immunoassay, clinical mass spectrometry, breath-based biopsies and digital morphology. We’ve been covering hot topics such as sepsis, hematological malignancies and Alzheimer's disease diagnostics.
So please visit our feature pages today and explore the interviews, articles and videos that we have been collating and creating for you. I’d love you to share anything that resonates with you on your social media channels and please use the hashtag clinical24. You can also share your own content using the clinical24 hashtag to add to the global digital discussion.
Finally, if you haven’t already done so, please remember to take our CLINICAL24 survey letting us know what challenges you face in your laboratory currently and how you’d like to learn about the solutions to overcome them. We’ll be using these insights to shape our editorial calendar for next year so we’d love to hear what is more useful for you. Enjoy the day, and thank you for being part of this landmark media campaign for the clinical industry.